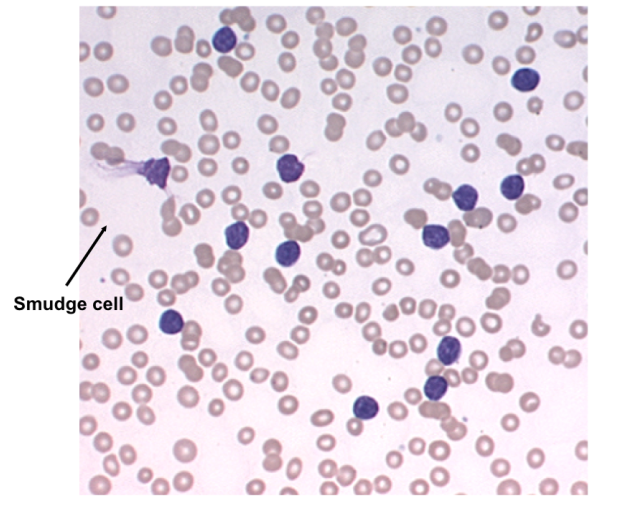
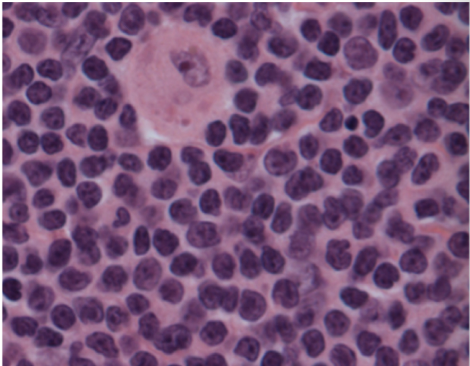

List 3 important causes of lymphadenopathy:
Reactive (benign) - e.g in response to immune system, cell type is stimulated and architecture is preserved
Lymphoma (either Hodgkin or Non-hodgkin)
Metastatic disease
Follicular hyperplasia:
Proliferation of B lymphocytes
Increased need for antibody production
Enlargement of germinal centers, with tingible-body macrophages and increased mitotic activity
E.g. enlarged cervical nodes in strep throat
Paracortical hyperplasia:
Proliferation of T lymphocytes
Increased need for cell-mediated immunity
Expansion of paracortical regions, with increased mitotic activity and activated lymphocytes
E.g. neck nodes in patient with infectious mono

Sinus histiocytosis:
Proliferation of histiocytes (aka tissue macrophages)
Stimulation of antigen-presenting cells
expansion of subcapsular/medullary sinuses
e.g. lymph nodes draining a carcinoma
Classically see this in patients with cancer

3 benign reactive causes of lymph node enlargement:
Follicular pattern (B cell proliferation)
Paracortical pattern (T cell proliferation)
Sinus histiocytosis (histiocytic proliferation)
Non-Hodgkin Lymphoma incidence and risk factors:
Highest in US, Australia, and Europe
Age
Infections
Immune disorders
Toxins
However, while risk factors are important, most patients have no identiafiable risk factor
How does the WHO classify lymphomas?
Based on the cell of origin.
E.g. breaks down into Hodgkin vs. Non-Hodgkin, then into B cell and T cell, further by e.g. precursor B cell neoplasms and Mature B cell neoplasms.
How does The Working Formulation classify lymphomas?
Low grade - can live years without treatment
Intermediate grade - can live a year
High grade - months of survival
______ is associated with an abnormal growth pattern in lymph node.
Lymphoma
Loss of architecture
(absence of germinal centers and sinuses)

What disease processes are indicated in these photos?

Left - Follicular Lymphpma (node contains dozens of enlarged follicles, caused by overexpression of BCL2)
Right - diffuse, characteristic of e.g. Diffuse Large B cell lymphoma, which can arise sporadically or from Follicular Lymphoma

SLL and CLL both:
Comprised of small, round lymphocytes
Occur in older adults
Have the same immunophenotype
Indolent but considered incurable
Explain the markers expressed on B cells in SLL:
Mature B cells, so:
CD19
CD20
CD22
CD23
BUT co-express CD5
Kappa OR lamda light chains
____ is associated with a good SLL prognosis.
____ is associated with a poor SLL prognosis.
13q14 is associated with a good SLL prognosis.
trisomy 12 is associated with a poor SLL prognosis.
What disease is suggested by this peripheral smear?
Could be CLL (chronic lymphocytic leukemia) or peripheral blood involvement by SLL (small lymphocytic lymphoma)
Follicular Lymphoma is commonly found in the ___ population. Characterized by WHAT mutation?
Found in adults.
Characterized by t(14;18) - this results in a BCL2 proto-oncogene translocated downstream of IgH gene regulatory sequences
Follicular Lymphoma causes an abnormal immunophenotype of _____ cells
Mature B cells
(cells resemble normal germinal center cells)
How is Follicular lymphoma treated? How can it progress if uncreated?
Indolent course - median survival 10 years
Incurable with conventional chemo
Patients typically present with high stage disease (including marrow involvement)
May progress to diffuse large cell lymphoma
What markers are present on B cells in patients with Follicular lymphoma?
CD19
CD20
CD22
CD10
Kappa OR lambda light chain
What disease is indicated by this bone marrow biopsy?
Mantle Cell Lymphoma
See numerous small lymphocytes with mixed in pink histiocytes (tissue macrophages).

What CD markers are present in patients with Mantle Cell Lymphoma?
Mature B cells positive for:
CD5
CD19
LAMBDA chain (almost always)
NEGATIVE FOR CD10 and CD23
Mantle Cell Lymphoma is associated with what diagnostic gene arrangement? What cellular processes result from this?
t(11;14)
Cyclin D1 gene from 11 is moved to IgG gene location on chromosome 14, resulting in high expression of cyclin D1.
Cyclin D1 promotes G1 –> S phase of cell cycle
Diffuse Large B-Cell Lymphoma occurs in what patient population?
All ages - children and adults
Can be associated with immune dysfunction (e.g. HIV, SCID, BM or organ transplants)
Diffuse Large B cell Lymphoma is often associated with an abnormal _____.
BCL-6
Can Diffuse B cell lymphoma be cured?
Yes - low stage disease can be cured